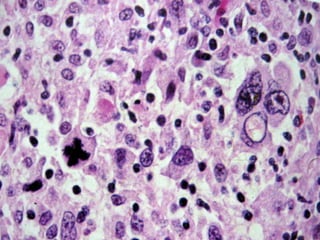

O documento discute vários tópicos relacionados a patologias da tireóide, incluindo: 1) Introdução sobre a anatomia e função da glândula tireóide; 2) Hipotireoidismo e hipertireoidismo, suas causas, sintomas e tratamentos; 3) Doenças inflamatórias da tireóide como diferentes tipos de tireoidite.